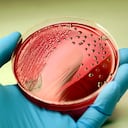
Colonies of a deadly bacteria Salmonella producing red colonies with black centre (hydrogen sulphide -H2S gas) on an XLD agar plate

El huevo es uno de los alimentos de la canasta familiar preferidos que acompaña los desayunos y cualquier tipo de comida en los hogares. Sin embargo, existe un debate sobre su regular consumo, por lo que el portal de salud Tua Saúde asegura que dentro de una dieta balanceada son muchos los beneficios que tiene este alimento, por ejemplo:
- Reduce la aparición de cáncer: gracias a las vitaminas A, D y E que lo componen, es una alimento rico en antioxidantes, mismos que eliminan los radicales libres que deterioran las células del cuerpo.

- Contribuye en la pérdida de peso porque tiene un efecto de llenura tras su consumo, reduciendo el apetito.
- Regula el colesterol; según el sitio web, tiene lecitina, que participa en el proceso metabólico, aumentando los índices de colesterol HDL que se considera bueno.
- Previene la anemia, una afección que se debe al déficit de glóbulos rojos que transportan oxígeno al organismo, por lo que es indispensable consumir alimentos ricos en hierro y, a su vez, en vitamina C que ayuda en la absorción de este.
- Fortalece el sistema óseo porque previene enfermedades que afectan los huesos como la osteoporosis, ya que es rico en fósforo y calcio.
- Contribuye en la salud ocular. El huevo tiene carotenoides, antioxidantes que tienen la capacidad de mantener el bienestar de los ojos.

¿Cuándo no consumir huevo?
Aunque parezca inofensivo, este alimento puede ser perjudicial para quienes son alérgicos a la albúmina, que es una proteína presente en la clara del huevo consumida en muchos casos como suplemento, que al pasar por un proceso, se convierte en polvo, que en su mayoría de veces es consumida por quienes entrenan.
Tampoco se sugiere que las mujeres en estado de embarazo consuman huevo crudo porque tienen altas probabilidades de contraer una infección. Lo anterior no quiere decir que solo las mujeres en este estado sean vulnerables, sino que cualquier persona lo es.
El huevo es rico en proteína, pero también tiene un alto índice calórico, por lo que no es recomendable en quienes pretenden bajar de peso. Por ende, se sugiere implementarlo en una dieta balanceada y, si es posible, bajo la supervisión de un nutricionista.

Adicionalmente, circula un comentario sobre la yema de huevo y su alto contenido en colesterol, una afirmación que, según Tua Saúde, rechaza porque, aunque sí es cierto que tiene un alto índice de colesterol, no trae desventajas a la salud, es decir, son mínimos sus riesgos.
Es de mencionar que el huevo es propenso a tener salmonella que, de acuerdo con la Administración de Alimentos y Medicamentos (FDA), causa enfermedades por intoxicación alimentaria.
¿Qué es la salmonella?
La salmonella es una enfermedad o infección que afecta los intestinos. De acuerdo con la Clínica Mayo, es una bacteria que se encuentra en los intestinos de los seres humanos y los animales, que es expulsada al evacuar.
Aquellos que tienen esta enfermedad experimentan calambres abdominales, diarrea y fiebre. Cabe indicar que, de acuerdo con la entidad americana de ciencia e investigación, esta infección puede ser adquirida al ingerir alimentos que están contaminados.
Algunas personas se recuperan pronto de la salmonela, pero otros necesitan asistencia médica para tratar esta enfermedad, que se puede expandir a otras zonas del organismo.
El consumo de carne, huevos o leche no pasteurizada, entre otros, pueden ser indicadores de que aparezca esta enfermedad, que puede manifestarse ya sea desde la sexta hora de haber sido adquirida o quizá a los seis días.
Otros síntomas que provoca esta enfermedad son: dolores de cabeza, náuseas, fiebre, retortijones en el estómago o sangre a la hora de evacuar.
